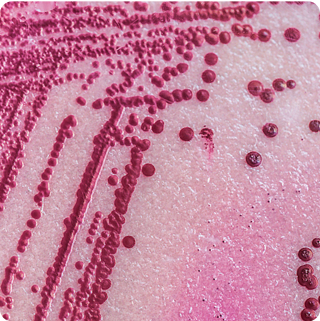

Salmonella & STEC - qPCR
SS
|
Turnaround Time:
2 - 4 days
|

Method Description
This combined test simultaneously detects Salmonella and Shiga toxin-producing E. coli (STEC), two of the most dangerous foodborne pathogens. Testing for both pathogens together is efficient and cost-effective for comprehensive food safety screening. Both organisms can cause severe illness and death, making their detection critical for protecting public health and preventing foodborne illness outbreaks.
Analyte List
Technical Data Sheet
Method Name
Microbial Analysis by qPCR
Method Code
LAB-TM-006
Equipment Type
Molecular Platform - qPCR
Equipment Details
Method Reference
Reportable Unit
CFU/g, Swabs: CFU/Sw
Sample Size Requirements
Available for
Food Products,
Dietary Supplements,
Botanicals (Raw Materials, Extracts, Finished Products),
API (Isolates, Active Ingredients)
Cannabis & Hemp (Plant Materials, Extracts, Isolates, MIPs)
Additional Information
Unavailable for
*Prices and offerings are subject to change without notice.